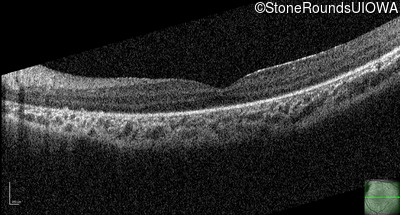
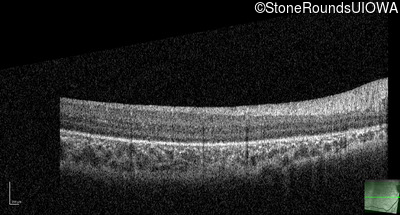
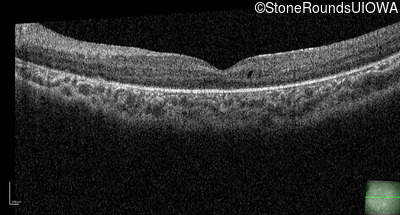
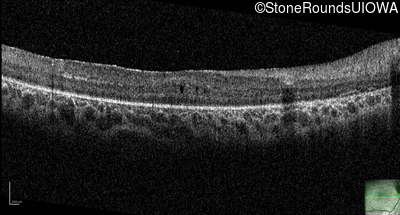
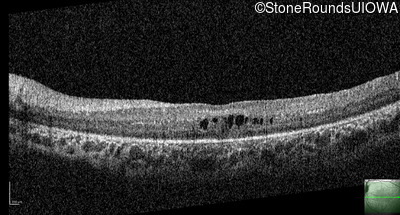

SR2626
Heimler Syndrome (IB8a)
Female
Female
SR2626
Student Mode
1Heimler Syndrome (IB8a)
2Female
Female
History
This four year old girl failed her newborn hearing screen and was fitted with hearing aids at 3 months of age. At age 3 she developed esotropia.
Diagnosis & molecular findings
| Disease | Gene | Allele 1 variant(s) | Allele 2 variant(s) | Inheritance mode |
|---|---|---|---|---|
| Heimler Syndrome | PEX1 | Gly843Asp GGT>GAT | Gly1044Arg GGA>AGA | AR |
Disease:
Gene:
Allele 1:
Gly843Asp GGT>GAT
Allele 2:
Gly1044Arg GGA>AGA
Inheritance:
AR